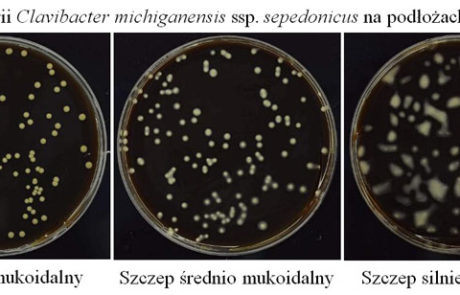

Zespół Diagnostyki Molekularnej i Biochemii
Pracownia Diagnostyki Molekularnej i Biochemii opracowuje nowe oraz optymalizuje istniejące metody diagnostyczne (immunologiczne i molekularne) służące do wykrywania najważniejszych pod względem ekonomicznym wirusowych i bakteryjnych patogenów ziemniaka. W Pracowni wytwarzane są poliklonalne przeciwciała królicze do wykrywania wirusów ziemniaka (PVY, PVM, PLRV, PVX, PVS) oraz przeciwciała do wykrywania bakterii Clavibacter michiganensis ssp. sepedonicus (Cms). W ramach diagnostyki molekularnej opracowywane są metody wykrywania patogenów ziemniaka za pomocą testu PCR oraz metod izotermicznej amplifikacji kwasów nukleinowych. Ponadto prowadzone są badania nad białkami ziemniaka posiadającymi potencjał użytkowy. Charakteryzowane są między innymi peroksydazy ziemniaczane, białka i peptydy o aktywności antybiotycznej oraz enzymy związane z odpowiedzią na stres biotyczny i abiotyczny. W Pracowni podejmowane są również badania nad wykorzystaniem profili białek i kwasów nukleinowych do różnicowania szczepów patogenów oraz identyfikacji odmian ziemniaka. Pracownia w 2006 roku opatentowała procedurę izolacji peroksydaz z wycierki ziemniaczanej a w ostatnich latach uzyskała siedem patentów (w tym jeden międzynarodowy) dotyczących diagnostyki bakterii Cms. W Pracowni od lat odbywają się praktyki studenckie dla studentów ostatnich lat kierunków o profilu biologicznym i biotechnologicznym.
- Opracowanie nowych i usprawnienie istniejących metod wykrywania wirusów ziemniaka (PVY, PVM, PLRV, PVX, PVS), wiroida wrzecionowatości bulw ziemniaka (PSTVd).
- Opracowanie czułych i specyficznych testów do wykrywania bakterii Clavibacter michiganensis ssp. sepedonicus.
- Wytwarzanie kropek kwantowych koloidów metali (złota, srebra, platyny i miedzi) oraz ich wykorzystanie w diagnostyce patogenów ziemniaka.
- Diagnostyka molekularna oparta o klasyczne metody amplifikacji kwasów nukleinowych PCR, oraz techniki izotermiczne LAMP.
- Wykorzystanie odpadów przemysłu ziemniacznego (wycierki, wód) do pozyskiwania cennych substancji białkowych, w tym peroksydaz, białkowych inhibitorów proteaz oraz białek o aktywności antybiotycznej względem mikroorganizmów chorobotwórczych dla roślin i człowieka.
- Prace nad metodami szybkiej identyfikacji odmian ziemniaka na podstawie profilu elektroforetycznego białek bulw ziemniaka oraz profilu DNA z zastosowaniem wzorców z kolekcji odmian utrzymywanej w banku genów ziemniaka.
- Poszukiwanie i charakterystyka enzymów, których aktywność może być markerem odporności odmian ziemniaka na stres biotyczny i abiotyczny.
- Badania nad ograniczeniem rozprzestrzeniania się bakteryjnych i grzybowych patogenów ziemniaka poprzez opracowywanie metod dezynfekcji powierzchni bulw, pomieszczeń, kontenerów i sprzętu rolniczego.
Prace nad wytwarzaniem nowych materiałów do diagnostyki bakterii Cms są obecnie prowadzone w ramach projektu LIDER, finansowanego przez Narodowe Centrum Badań i Rozwoju (NCBiR). W pracowni realizowane są obecnie również dwa projekty finansowane przez Ministerstwo Rolnictwa w ramach programu Postęp Biologiczny w Produkcji Roślinnej (projekt dotyczący opracowania metod selektywnej izolacji i identyfikacji bakterii Cms w trudnych diagnostycznie próbach środowiskowych oraz projekt dotyczący diagnostyki wirusów). Również w przeszłości w Pracowni zrealizowano szereg projektów badawczych finansowanych przez Ministerstwo Nauki a jeszcze wcześniej przez KBN. Od 2002 roku Pracownia nieprzerwanie bierze aktywny udział w projektach finansowanych przez Ministerstwo Rolnictwa.
dr hab. Krzysztof Treder – Kierownik Zespołu
e-mail: k.treder@ihar.edu.pl
tel.: (94) 342 30 31 w. 207
Pracownicy:
dr Paulina Dederko
email: p.dederko@ihar.edu.pl
tel.: 94 342 30 31 w. 272
mgr inż. Anna Pawłowska
email: a.pawlowska@ihar.edu.pl
tel.: 94 342 30 31 w. 229
mgr inż. Wioleta Stochła – Potentas
email: w.stochla@ihar.edu.pl
tel.: 94 342 30 31 w. 244
tech. Maria Fedczak
tel.: 94 342 30 31 w. 241
tech. Alicja Przewłoka
tel.: 94 342 30 31 w. 241
potatoMETAbiome
Tytuł: „Wykorzystanie interakcji ziemniak-mikrobio m do opracowania strategii zrównoważonej hodowli i produkcji ziemniaka” – międzynarodowy projekt badawczy „ potatoMETAbiome” Pobierz załącznik PDF Pobierz załącznik 2 PDF
Zwiększenie konkurencyjności polskich towarów …
Tytuł: Zwiększenie konkurencyjności polskich towarów roślinnych na rynkach międzynarodowych poprzez podniesienie ich jakości i bezpieczeństwa fitosanitarnego FITOEXPORT Okres realizacji: 2019-2021 Kierownik projektu: dr Janina Butrymowicz Projekt współfinansowany przez Narodowe Centrum Badań i Rozwoju w ramach strategicznego [...]
Grant NCN, uzyskany w konkursie OPUS 11
Tytuł: Dynamika transportu i replikacji najważniejszych szczepów wirusa Y ziemniaka w pierwotnie oraz wtórnie porażonych roślinach ziemniaka" Tytuł angielski: The dynamics of transport and replication of the most important strains of Potato virus Y in primarily and [...]
Opracowanie czułych metod …
Projekty badawcze finansowane z Programu Ministerstwa Rolnictwa i Rozwoju Wsi - Postęp Biologiczny w Produkcji Roślinnej: Tytuł: Opracowanie czułych metod wykrywania najważniejszych wirusów ziemniaka Instytucja finansująca: MRiRW, program PBwPR Okres realizacji: 2014-2020 Kierownik projektu: dr Krzysztof Treder Jednostka realizująca: Zakład [...]
Badania nad opracowaniem metod selektywnej ….
Projekt badawczy finansowany z Programu Ministerstwa Rolnictwa i Rozwoju Wsi - Postęp Biologiczny w Produkcji Roślinnej Tytuł: Badania nad opracowaniem metod selektywnej izolacji oraz czułej identyfikacji bakterii Clavibacter michiganensis ssp. sepedonicus (Clavibacter michiganensis ssp. sepedonicus ) w trudnych diagnostycznie próbach [...]
LIDER 28/199/L-3/11/NCBR/2012
Projekty badawcze finansowane przez Narodowe Centrum Badań i Rozwoju: Numer: LIDER 28/199/L-3/11/NCBR/2012 Tytuł: Nowe narzędzie diagnostyczne o wysokiej czułości i specyficzności do wykrywania i identyfikacji kwarantannowej bakterii Clavibacter michiganensis ssp. sepedonicus. Instytucja finansująca: NCBiR Okres realizacji: 2011-2015 Kierownik projektu: dr inż. Włodzimierz Przewodowski [...]
NCN N N310 728540
Tytuł: Opracowanie procedury izolacji wirusów roślinnych przy użyciu membranowej chromatografii jonowymiennej Okres realizacji: 2010-2014 Kierownik projektu: dr inż. Agnieszka Przewodowska Wartość projektu: 270 000, 00 PLN
N N310 144235
Tytuł: Optymalizacja nowych immunologicznych metod wykrywania bakterii Clavibacter michinganensis subsp. sepedonicus Okres realizacji: 10.09.2008 – 09.09.2011 Kierownik projektu: dr inż. Włodzimierz Przewodowski Wartość projektu: 278 000,00 PLN
2 PO6A 023 30
Praca doktorska wykonana w ramach tego projektu przez dr inż. Włodzimierza Przewodowskiego została wyróżniona przez Radę Naukową IHAR-PIB. Tytuł: Opracowanie zestawów diagnostycznych do wykrywania bakterii Clavibacter michiganensis sups. sepedonicus - sprawcy bakteriozy pierścieniowej ziemniaka. Okres realizacji: 02.06.2005 [...]
2P06 008 26
Tytuł: Opracowanie procedur wykrywania wirusów PLRV, PVY, PVY, PVM, PVS, PVX, bezpośrednio w bulwach ziemniaka. Okres realizacji: 15.03.2004 – 14.03.2006 Kierownik projektu: dr Krzysztof Treder Wartość projektu: 153 000,00 PLN
P06A 031 18
Praca doktorska wykonana w ramach tego projektu przez dr Krzysztofa Tredera została wyróżniona przez Radę Naukową IHAR-PIB i zdobyła nagrodę Prezesa Rady Ministrów za wyróżnione rozprawy doktorskie. Tytuł: Wpływ proteolitycznej modyfikacji cząstek wirusa liściozwoju ziemniaka w [...]
5P06A 011 14
Tytuł: Molekularne mechanizmy antagonistycznego oddziaływania bakterii Pseudomonas fluorescens na Phytophtora infestans Okres realizacji: 02.01.1998 – 31.12.2000 Kierownik projektu: dr hab. Jerzy Lewosz Wartość projektu: 177 000,00 PLN
5P06A 007 12
Tytuł: Molekularne mechanizmy antagonistycznego oddziaływania bakterii Pseudomonas fluorescens na Phytophtora infestans. Optymalizacja procedur wykrywania sprawcy bakteriozy pierścieniowej ziemniaka (Clavibacter michiganensis ssp. sepedonicus) w weryfikacji nasiennej Okres realizacji: 01.02.1997 – 30.12.1998 Kierownik projektu: dr hab. Jerzy Lewosz Wartość projektu: 177 000,00 PLN
Opracowanie procedury …
Projekty z Programu MRiRW "Postęp Biologiczny w Produkcji Roślinnej" Tytuł: Opracowanie procedury wykrywania infekcji wirusowych w bulwach ziemniaka bezpośrednio po zbiorze lub w stanie spoczynku Kierownik projektu: w latach 2008-2010 - dr Krzysztof Treder Kierownik projektu: w latach [...]
5P06A 007 12
Tytuł: Badania na rzecz ograniczenia rozprzestrzeniania się Clavibacter michiganensis ssp. sepedonicus w materiałach wyjściowych hodowli ziemniaka Okres realizacji: 01.02.1997 – 30.12.1998 Kierownik projektu: w latach 2008-2010 - dr Krzysztof Treder Kierownik projektu: w latach 2011-2013 - dr inż. Włodzimierz Przewodowski Wartość projektu: 2105000, 00 [...]
Badania na rzecz ograniczenia …
Tytuł: Badania na rzecz ograniczenia rozprzestrzeniania się Clavibacter michiganensis ssp. sepedonicus w materiałach wyjściowych do hodowli ziemniaka. Okres realizacji: 2003-2007 Kierownik projektu: dr hab. Jerzy Lewosz
Idenentyfikacja czystości i jednorodności genotypowej …
Tytuł: Idenentyfikacja czystości i jednorodności genotypowej roślin ziemniaka w materiałach hodowlanych podczas mikropropagacji in vitro Okres realizacji: 2003-2007 Kierownik projektu: dr hab. Jerzy Lewosz
2P06T 054 30
W Pracowni Diagnostyki Molekularnej i Biochemii wykonano cześć badań realizowanych w ramach projektów badawczych Politechniki Koszalińskiej: Tytuł: Opracowanie metod wydzielania antygrzybowych i antybakteryjnych peptydów z ścian komórkowych bulw ziemniaka i poznanie ich właściwości fizyko-chemicznych i biologicznych. [...]
N N312 1466 33
Tytuł: Oddziaływanie niektórych peptydów ścian komórkowych bulw ziemniaka na mikroflorę surowców roślinnych i żywności o małym stopniu przetworzenia. Okres realizacji: 25.09.2007-24.03.2009 Kierownik projektu: dr hab. Jerzy Lewosz Główny wykonawca: mgr. inź. Agnieszka Barnyk
- 2016. Patent europejski przyznany przez EPO nr EP 2 205 735. “Immunological tests for the presence of bacteria which make use of antibodies obtained using a specific method”-W.Przewodowski.
- Patent US 12/676 671 . “Immunological tests for the presence of bacteria which make use of antibodies obtained using a specific method” Przyznany 17.09.2013r. przez Urząd Patentowy USA (USPTO). (Podstawa – międzynarodowe zgłoszenie patentowe PCT/PL2008/050015 WIPO-Genewa). Twórca: dr inż. Włodzimierz Przewodowski.
- Patent P 383366 . Zestaw do wykrywania albo przeżyciowego izolowania bakterii Clavibacter michiganensis ssp. sepedonicus w analizowanej próbce. Przyznany 12.09.2012r decyzją UP RP. Twórca: dr inż. Włodzimierz Przewodowski.
- Patent P 383365 . Zestaw inkubacyjny do wykrywania albo przeżyciowego izolowania wybranych bakterii, w szczególności Clavibacter michiganensis ssp. sepedonicus. Przyznany 12.09.2012r decyzją UP RP. Twórca: dr inż. Włodzimierz Przewodowski.
- Patent P 383364 . Sposób wykrywania obecności bakterii Clavibacter michiganensis ssp. sepedonicus z wykorzystaniem membran poliwęglanowych zawierających immobilizowane przeciwciała. Przyznany 12.09.2012r decyzją UP RP. Twórca: dr inż. Włodzimierz Przewodowski.
- Patent P 383363 . Sposób wykrywania obecności bakterii Clavibacter michiganensis ssp. sepedonicus w analizowanej próbce. Przyznany 12.09.2012r decyzją UP RP. Twórca: dr inż. Włodzimierz Przewodowski.
- Patent P 383361 . Test immunologiczny na obecność bakterii. Przyznany 25.03.2011r. decyzją UP RP. Twórca: dr inż. Włodzimierz Przewodowski.
- Patent P 383362 . Sposób usuwania śluzów bakteryjnych. Przyznany 24.03.2011r. decyzją UP RP. Twórcy: dr inż. Włodzimierz Przewodowski, dr hab. Jerzy Lewosz
- Patent PL 195200 B1 . Sposób otrzymywania peroksydazy z wycierki ziemniaczanej. Przyznany 31.08.2007r. decyzją UP RP. Twórca: dr hab. Jerzy Lewosz.
2017
- Stochła W., Przewodowski W., Przewodowska A., Salamońska K. 2017. Immunodiagnostyczne metody wykrywania i identyfikacji bakteryjnych patogenów ziemniaka. Ziemniak Polski 1: 14-20.
- Szarek D. Przewodowska A. 2017. Patatyna – Białko ziemniaka o cennych właściwościach. Ziemniak Polski 1: 32-36
- Kurnik K., Krzyżyński M., Treder K., Tretyn A., Tyburski J. 2017. Study on utilizing solid food industry waste with brewers’ spent grain and potato pulp as possible peroxidase sources. J. Food Biochem. doi:10.1111/jfbc.12446.
- Treder K., Zacharzewska B. 2017. Opracowanie nowych starterów do wykrywania wirusa M ziemniaka (Potato virus M, PVM) za pomocą testu RT-PCR. Ziemniak Polski, 3: 32-35.
- Wróbel S., Kęsy J., Treder K. 2017. Effect of growth regulators and ethanol on termination of dormancy in potato tubers. Am. J. Potato Res. doi:10.1007/s12230-017-9592-2.
- Kurnik K., Treder K., Twarużek M., Grajewski A., Tretyn A., Tyburski J. 2017. Potato pulp as the peroxidase source for 2,4-dichlorophenol removal. Waste Biomass Valor. doi:10.1007/s12649-017-9863-7.
- Przewodowski W, Przewodowska A. 2017. Development of a sensitive and specific polyclonal antibody for serological detection of Clavibacter michiganensis subsp. sepedonicus. PLoS ONE 12(1):e0169785.doi:10.1371/journal.pone.0169785.
2016
- Gryń G, Pastuszewska T., Przewodowski W. 2016. Ocena patogeniczności wybranych szczepów Clavibacter michiganensis subsp. sepedonicus pochodzących z kolekcji NCPPB w Wielkiej Brytanii. Progress in Plant Protection / Postępy w Ochronie Roślin 56: 73-78.
- Treder K., Pawłowska A., Chołuj J. 2016. Identyfikacja odmian ziemniaka za pomocą elektroforezy natywnej białek i molekularnego testu ISAP. Ziemniak Polski, 4: 21-27.
2015
- Treder K. 2015. Metody wykrywania obecności wirusów ziemniaka. Ziemniak Polski, 4: 18-23.
- Przewodowska A., Zacharzewska B., Chołuj J., Treder K. 2015. A one-step, real-time reverse transcription loop-mediated isothermal amplification assay to detect potato virus Y. Am. J. Potato. Res. 92: 303-311.
- Kurnik K., Treder K., Skorupa-Kłaput M., Tretyn A.,Tyburski J. 2015. Removal of phenol from synthetic and industrial waste water by potato pulp peroxidases. Water Air Soil Pollut. 2015; 226(8): 254. doi: 10.1007/s11270-015-2517-0.
- Treder K., Zacharzewska B., Przewodowska A., Przewodowski W., Otulak K. 2015. Ion-exchange membrane chromatography as an alternative method of separation of potato Y virus. Plant Breeding and Seed Science 72: 56-67.
- Wróbel S., Kęsy J., Treder K. 2015. Effect of ethanol and plant growth regulators on termination of potato microtuber dormancy. Plant Breeding and Seed Science 71: 23-36.
- Przewodowski W., Chołuj J., Przewodowska A. 2015. Wpływ różnych sposobów izolacji kwasów nukleinowych z bakterii na czułość testu PCR. Progress in Plant Protection / Postępy w Ochronie Roślin 55: 321-326. DOI: 10.14199/ppp-2015-056.
- Stochła W., Przewodowska A., Przewodowski W. 2015. Przydatność przeciwciał króliczych uzyskiwanych dwiema metodami do wykrywania Clavibacter michiganensis subsp. sepedonicus testem DAS-ELISA. Progress in Plant Protection / Postępy w Ochronie Roślin 55: 352-357.
- Pietraszko M., Gryń G., Pastuszewska T., Przewodowski W., Przewodowska A. 2015. Podatność wybranych odmian ziemniaka na porażenie bakteriami Clavibacter michiganensis subsp. sepedonicus w zróżnicowanych warunkach glebowych. Biuletyn IHAR 277: 99-108.
- Stochła W., Przewodowska A., Przewodowski W. 2015. Wykrywanie bakterii Clavibacter michiganensis subsp. sepedonicus przy użyciu przeciwciał króliczych uzyskiwanych dwoma różnymi sposobami. Prog. Plant Prot. 55, 3: 352-357.
- Przewodowski W., Chołuj J., Przewodowska A. 2015. Wpływ różnych sposobów izolacji kwasów nukleinowych z bakterii na czułość testu PCR. Prog. Plant Prot. 55, 3: 321-326.
- Przewodowska A., Zacharzewska B., Chołuj J., Treder K. 2015. A one-step, real-time reverse transcription loop-mediated isothermal amplification assay to detect Potato virus Y. American Journal of Potato Research. Doi: 10.1007/s12230-015-9430-3.
2014
- Zacharzewska B., Przewodowska A., Treder K. 2014. The adaptation of silica capture RT-PCR for the detection of potato virus Y. American Journal of Potato Research, 91: 525-531.
- Chołuj J., Przewodowski W. 2014. Technika PCR i jej modyfikacje w identyfikacji patogenów ziemniaka. Ziemniak Polski, 24(3): 40-45.
- Pawłowska A., Treder K. 2014. Peroksydazy-małe enzymy o wielkim znaczeniu. Ziemniak Polski, 24(1).
- Zacharzewska B., Treder K. 2014. Test ELISA jego modyfikacje. Ziemniak Polski, 24(1).
- Przewodowski W., Chołuj J., Przewodowska A., Treder K. 2014. Detection of Clavibacter michiganensis subsp. sepedonicus using Loop-Mediated Isothermal Amplification. Abstract of XVI International Congress on Molecular Plant-Microbe Interactions. P209: 67
2013
- Treder K., Przewodowska A. 2013. Application of RT-LAMP for direct detection of potato viruses in dormant tubers. Acta Phytopathologica Sinica, 43: 448. Streszczenie posteru.
- Przewodowska A, Przewodowski W., Treder K. 2013. Ion-exchange membrane chromatography – a new tool for plant virus purification. Acta Phytopathologica Sinica, 43: 448-449. Streszczenie posteru.
- Przewodowski W., Przewodowska A. and Treder K. 2013. Application of colloidal metal nanoparticles in diagnosis of quarantine bacteria – Clavibacter michiganensis subsp. sepedonicus. Abstract 10th International Congress of Plant Pathology. Acta Phytopathologica Sinica 43: 370.
2012
- Przewodowski W., Przewodowska A. 2012. Wykorzystanie biochemicznych i molekularnych metod w diagnostyce patogenów oraz identyfikacji jednorodności odmianowej ziemniaka. s. 57-66. W: „Produkcja i rynek ziemniaka” (J. Chotkowski, red.). Wydawnictwo Wieś Jutra, Warszawa, 340.
- Przewodowska A., Treder K. 2012. Purification of plant viruses by membrane ion-exchange chromatography. New Biotechnology, 29: S133. Streszczenie posteru.
2011
- Waleron M., Waleron K., Kamasa J., Przewodowski W., Lojkowska E. 2011. Polymorphism analysis of housekeeping genes for identification and differentiation of Clavibacter michiganensis subspecies. Eur. J. Plant Pathol. 131:341–354.
2010
- Pilecki T., Treder K. 2010. Wpływ okresu przechowywania ziemniaków na wykrywalność wirusów PLRV, PVM oraz PVY w bulwach. Prog. Plant Prot./Post. Ochr. Roślin, 50: 723–727.
- Przewodowski W. 2010. Antimicrobial influence of colloidal nanoparticles on quarantine pathogen Clavibacter michiganensis ssp. sepedonicus. New Biotechnology – Abstracts of the 15th European Congress on Biotechnology 29: 132
- Przewodowski W., Barnyk A. 2010. Nowe metody diagnostyczne do wykrywanie fitopatogennych bakterii ziemniaka. Ziemniak Polski, 1: 1-4.
2009
- Barnyk A., Przewodowski W., Treder K. 2009. Ziemniak jako źródło peptydów i białek o działaniu antybakteryjnym oraz antygrzybowym. Ziemniak Polski, 19: 38-40.
- Pilecki T., Barnyk A., Przewodowski W., Treder K. 2009. Wpływ inhibitorów reakcji niespecyficznej adsorpcji przeciwciał i składu buforów na wykrywalność wirusów w bulwach ziemniaka. Prog. Plant Prot./Post. Ochr. Roślin, 49: 691–695.
- Przewodowski W., Barnyk A. 2009. Szybki test diagnostyczny do wykrywania bakterii Clavibacter michiganensis ssp. sepedonicus. Prog. Plant Prot.49 : 696-700.
- Przewodowski W. 2009. Nowe metody diagnostyczne do wykrywania bakterii Clavibacter michiganensis ssp. sepedonicus. Prog. Plant Prot. 49: 1335-1343.
- Treder K., Pilecki T., Łycuś P. 2009. Wykrywanie wirusów ziemniaczanych bezpośrednio w ekstraktach z bulw – porównanie testu ELISA z immuno-captured RT-PCR. Prog. Plant Prot./Post. Ochr. Roślin, 49: 740745 .
- Treder K., Przewodowski W., Barnyk A. 2009. Factors influencing detection of potato leafroll virus and potato virus Y in potato tuber extracts. Plant Breeding and Seed Science, 59: 65-74.
- Treder K., Przewodowski W. 2009. Poprawa czułości wykrywania wirusów ziemniaka testem ELISA dzięki zwiększeniu adsorpcyjności mikropłytek poprzez mycie w proszku do prania. Prog. Plant Prot./Post. Ochr. Roślin, 49: 1767-1769.
- Barnyk A., Przewodowski W., Treder K. 2009. Wpływ białek ziemniaka na wzrost wybranych drobnoustrojów chorobotwórczych. Prog. Plant Prot./Post. Ochr. Roślin, 49: 890–893.
- Barnyk A., Przewodowski W., Treder K. 2009. Ziemniak jako źródło peptydów i białek o działaniu antybakteryjnym oraz antygrzybowym. Ziemniak Polski, 19: 38-40.
- Pilecki T., Barnyk A., Przewodowski W., Treder K. 2009. Wpływ inhibitorów reakcji niespecyficznej adsorpcji przeciwciał i składu buforów na wykrywalność wirusów w bulwach ziemniaka. Prog. Plant Prot./Post. Ochr. Roślin, 49: 691–695.
- Przewodowski W., Barnyk A. 2009. Szybki test diagnostyczny do wykrywania bakterii Clavibacter michiganensis ssp. sepedonicus. Prog. Plant Prot.49 : 696-700.
- Przewodowski W. 2009. Nowe metody diagnostyczne do wykrywania bakterii Clavibacter michiganensis ssp. sepedonicus. Prog. Plant Prot. 49: 1335-1343.
- Treder K., Pilecki T., Łycuś P. 2009. Wykrywanie wirusów ziemniaczanych bezpośrednio w ekstraktach z bulw – porównanie testu ELISA z immuno-captured RT-PCR. Prog. Plant Prot./Post. Ochr. Roślin, 49: 740745 .
2008
- Barnyk A., Lewosz J., Treder K., Przewodowski W., Pilecki T. 2008. Zastosowanie chromatografii tiofilnej do izolacji przeciwcial poliklonalnych z surowicy krwi krolikow. Biuletyn Instytutu Hodowli i Aklimatyzacji Roślin, 248: 87-95.
- Przewodowski W., Treder K. 2008. Trudności związane z diagnozą i identyfikacją bakteriozy pierścieniowej ziemniaka. Ziemniak Polski, 18 (4).
- Pilecki T., Treder K., Lewosz J. 2008. Detection of PVY, PVM and PLRV in the sap of dormant tubers by cocktail ELISA. Acta Biochimica Polonica 55 (3): 171. Streszczenie posteru.
2007
- Przewodowski W., Lewosz J., Treder K., Barnyk A., Pilecki T. 2007. Identyfikacja odmian ziemniaka metodą elektroforetyczną. Biuletyn Instytutu Hodowli I Aklimatyzacji Roślin, 243: 151-157.
2001
- Treder K., Lewosz J. 2001. Production of antibodies against Potato leafroll virus coat protein expressed in Escherichia coli as an antigen. W: Proceedings of ‘The 11th EAPR Virology Section Meeting’, Triest, Czech Republic, pp. 62-64.
2000
- Pilecka A., Lewosz J., Treder K. 2000. Charakterystyka antymikrobiologicznej aktywnosci niektorych polipeptydow scian komorkowych ziemniaka. Prog. Plant Prot./Post. Ochr. Roślin, 40: 188-194.
- Treder K., Lewosz J. 2000. Zastosowanie metod molekularnych do wykrywania wirusa liściozwoju ziemniaka (PLRV). Prog. Plant Prot./Post. Ochr. Roślin, 40: 177-187.
- Treder K., Lewosz J. 2000. Detection of PLRV and PVY in dormant potato tubers by cocktail and amplified ELISA assay. W: Report of the joint meeting of the Potato Section of EUCARPIA and the Section Breeding and varietal assessment of the EAPR, 3-7 July, 2000, Warsaw (Poland). Potato Research 43: 424. Streszczenie posteru.
- Lewosz J. Hołubowska M. 2000. Zastosowanie par kwasu propionowego do eliminacji chorób skórki bulw ziemniaka podczas przechowywania. Ziemniak Polski 3:23-28.
- Pastuszewska T., Sadoch Z., Lewosz J. 2000. Warunki wykrywania Clavibacter michiganensis ssp. sepedonicus w roslinach ziemniaka na podstawie reakcji PCR. Progress in Plant Protection – Postepy w Ochronie Roślin, 40: 615-618.
1998
- Treder K., Lewosz J. 1998. Isolation of 17, 23 and 56 KD proteins from potato leafroll particles and some evidence for their proteolytic modification. W: Proceedings of 10 th EAPR Virology Section Meeting, Baden Austria 5-10 July 1998. 175-180.
- Lewosz J., Hołubowska M. 1998. Eradication of pathogenic micro-organisms on the tuber skin during storage and inhibition of tuber sprouting by volatile carboxylic acids. 1998. Potato Res. 41: 197-198.
- Lewosz J., Hołubowska M, Urbaniak A, Treder K. 1998. Activity of nitrate reductase in potato leaves as an indicator of tolerance to herbicides and abiotic stress. Beitrage zur Zuchtungsforschung, 4:109-116 .
- Lewosz J. Normy i metody badań zawartości substancji szkodliwych. 1998. Rozdz. 11.3 W: „Produkcja Ziemniaków; Technologia – Ekonomika – Marketing”. Praca. zbiorowa pod red. J. Chotkowskiego. Wyd. Instytut Ziemniaka Bonin 1998.
1997
- Pastuszewska T., Mierzwa Z, Lewosz J., Burkiewicz A. 1997. Wykrywanie bakterii Clavibacter michiganensis subsp. sepedonicus w bulwach ziemniaka metodami IFAS i PCR. Progress in Plant Protection – Postępy w Ochronie Roślin, 37:336-339.
1995
- Lewosz J., Pastuszewska T., 1995. Action of phtalocyanine on the exopolysaccharides, detectability and survival of Clavibacter michiganensis ssp, sepedonicus. EPPO Bulletin 25:177-184.
- Wykrywanie wirusów ziemniaka (PVY, PVM, PLRV, PVS, PVX) i wiroida wrzecionowatości bulw ziemniaka (PSTVd) za pomocą metod molekularnych (RT-PCR, RT-LAMP).
- Identyfikacja odmian ziemniaka za pomocą elektroforezy natywnej białek soku bulw ziemniaka. Identyfikacja pozwala na potwierdzenie lub wykluczenie tożsamości badanych bulw poprzez porównanie z odmianami wzorcowymi.
- Możliwość odbywania praktyk studenckich dla studentów ostatnich lat kierunków o profilu biotechnologicznym i biologicznym oraz staży dla absolwentów tych kierunków.
Nasze zespoły

Zespół Diagnostyki
Molekularnej i Biochemii

Zespół Nasiennictwa
Ziemniaka

Zespół Banku
Genów Ziemniaka

Zespół
Ochrony Ziemniaka